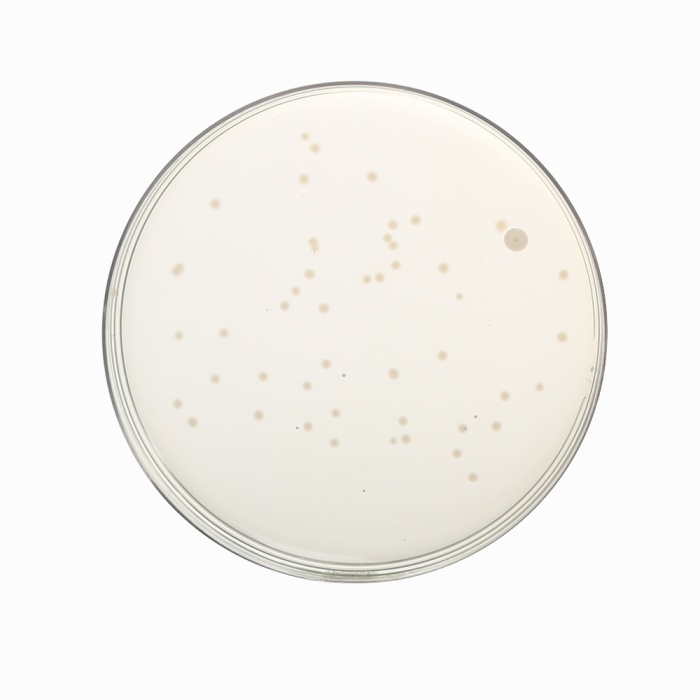
Luria Bertani Agar, Modified,  Granulated

Your enquiry has been submitted
Luria Bertani Agar, Modified
Composition
| Ingredients | Gms/Litre |
|---|---|
| Casein enzymic hydrolysate | 10.000 |
| Yeast extract | 5.000 |
| Sodium chloride | 5.000 |
| Agar | 10.000 |
Final pH (at 25°C): 7.2±0.2
**Formula adjusted, standardized to suit performance parameters
Directions
Suspend 30 grams in 1000 ml distilled water. Heat to boiling to dissolve the medium completely. Sterilize by autoclaving at 15 lbs pressure (121°C) for 15 minutes. Dispense as desired.
Principle And Interpretation
Luria Bertani Agar, Modified is prepared as described by Lennox (1) for cultivation and maintenance of recombinant strains of Escherichia coli. The medium is nutritionally rich for the growth of pure cultures of recombinant strains. Strains generally derived from Escherichia coli K12 are deficient in Vitamin B synthesis which are further modified by specific mutation to create auxotrophic strains and are unable to grow on nutritionally deficient media.
Casein enzymic hydrolysate provides peptides and peptones while Vitamin B complex is provided by yeast extract. Sodium chloride provides sodium ions for the membrane transport and maintains osmotic equilibrium of the medium.
Quality Control
Appearance: Cream to yellow Homogeneous Free flowing powder
Gelling: Firm, comparable with 1.0% Agar gel.
Colour and Clarity of prepared medium: Yellow to amber Clear to slightly opalescent
Reaction: Reaction of 3.0% w/v aqueous solution at 25°C. pH: 7.2±0.2
pH: 7.00-7.40
Cultural Response
Cultural characteristics observed after an incubation at 35-37°C for 18-24 hours.
Cultural Response
| Organism | Inoculum (CFU) | Growth | Recovery |
|---|---|---|---|
| Escherichia coli ATCC 23724 | 50-100 | luxuriant | >=70% |
| Escherichia coli ATCC 25922 | 50-100 | luxuriant | >=70% |
Storage and Shelf Life
Store below 30°C in tightly closed container and the prepared medium at 2-8°C. Use before expiry date on the label.
Reference
- Lennox E.S., 1955, Transduction of Linked Genetic Characters of the host by bacteriophage P1., Virology, 1:190.
- Atlas R.M., 1993, Handbook of Microbiological Media, Ed. by Parks L., CRC Press, Inc.
| Product Name | Luria Bertani Agar, Modified |
|---|---|
| SKU | M1151F |
| Product Type | Regular |
| Physical Form | Powder |
| Origin | Animal |
| Packaging type | HDPE |
| References | 1.Lennox E.S., 1955, Transduction of Linked Genetic Characters of the host by bacteriophage P1., Virology, 1:190. |
| Customized Product Available | No |